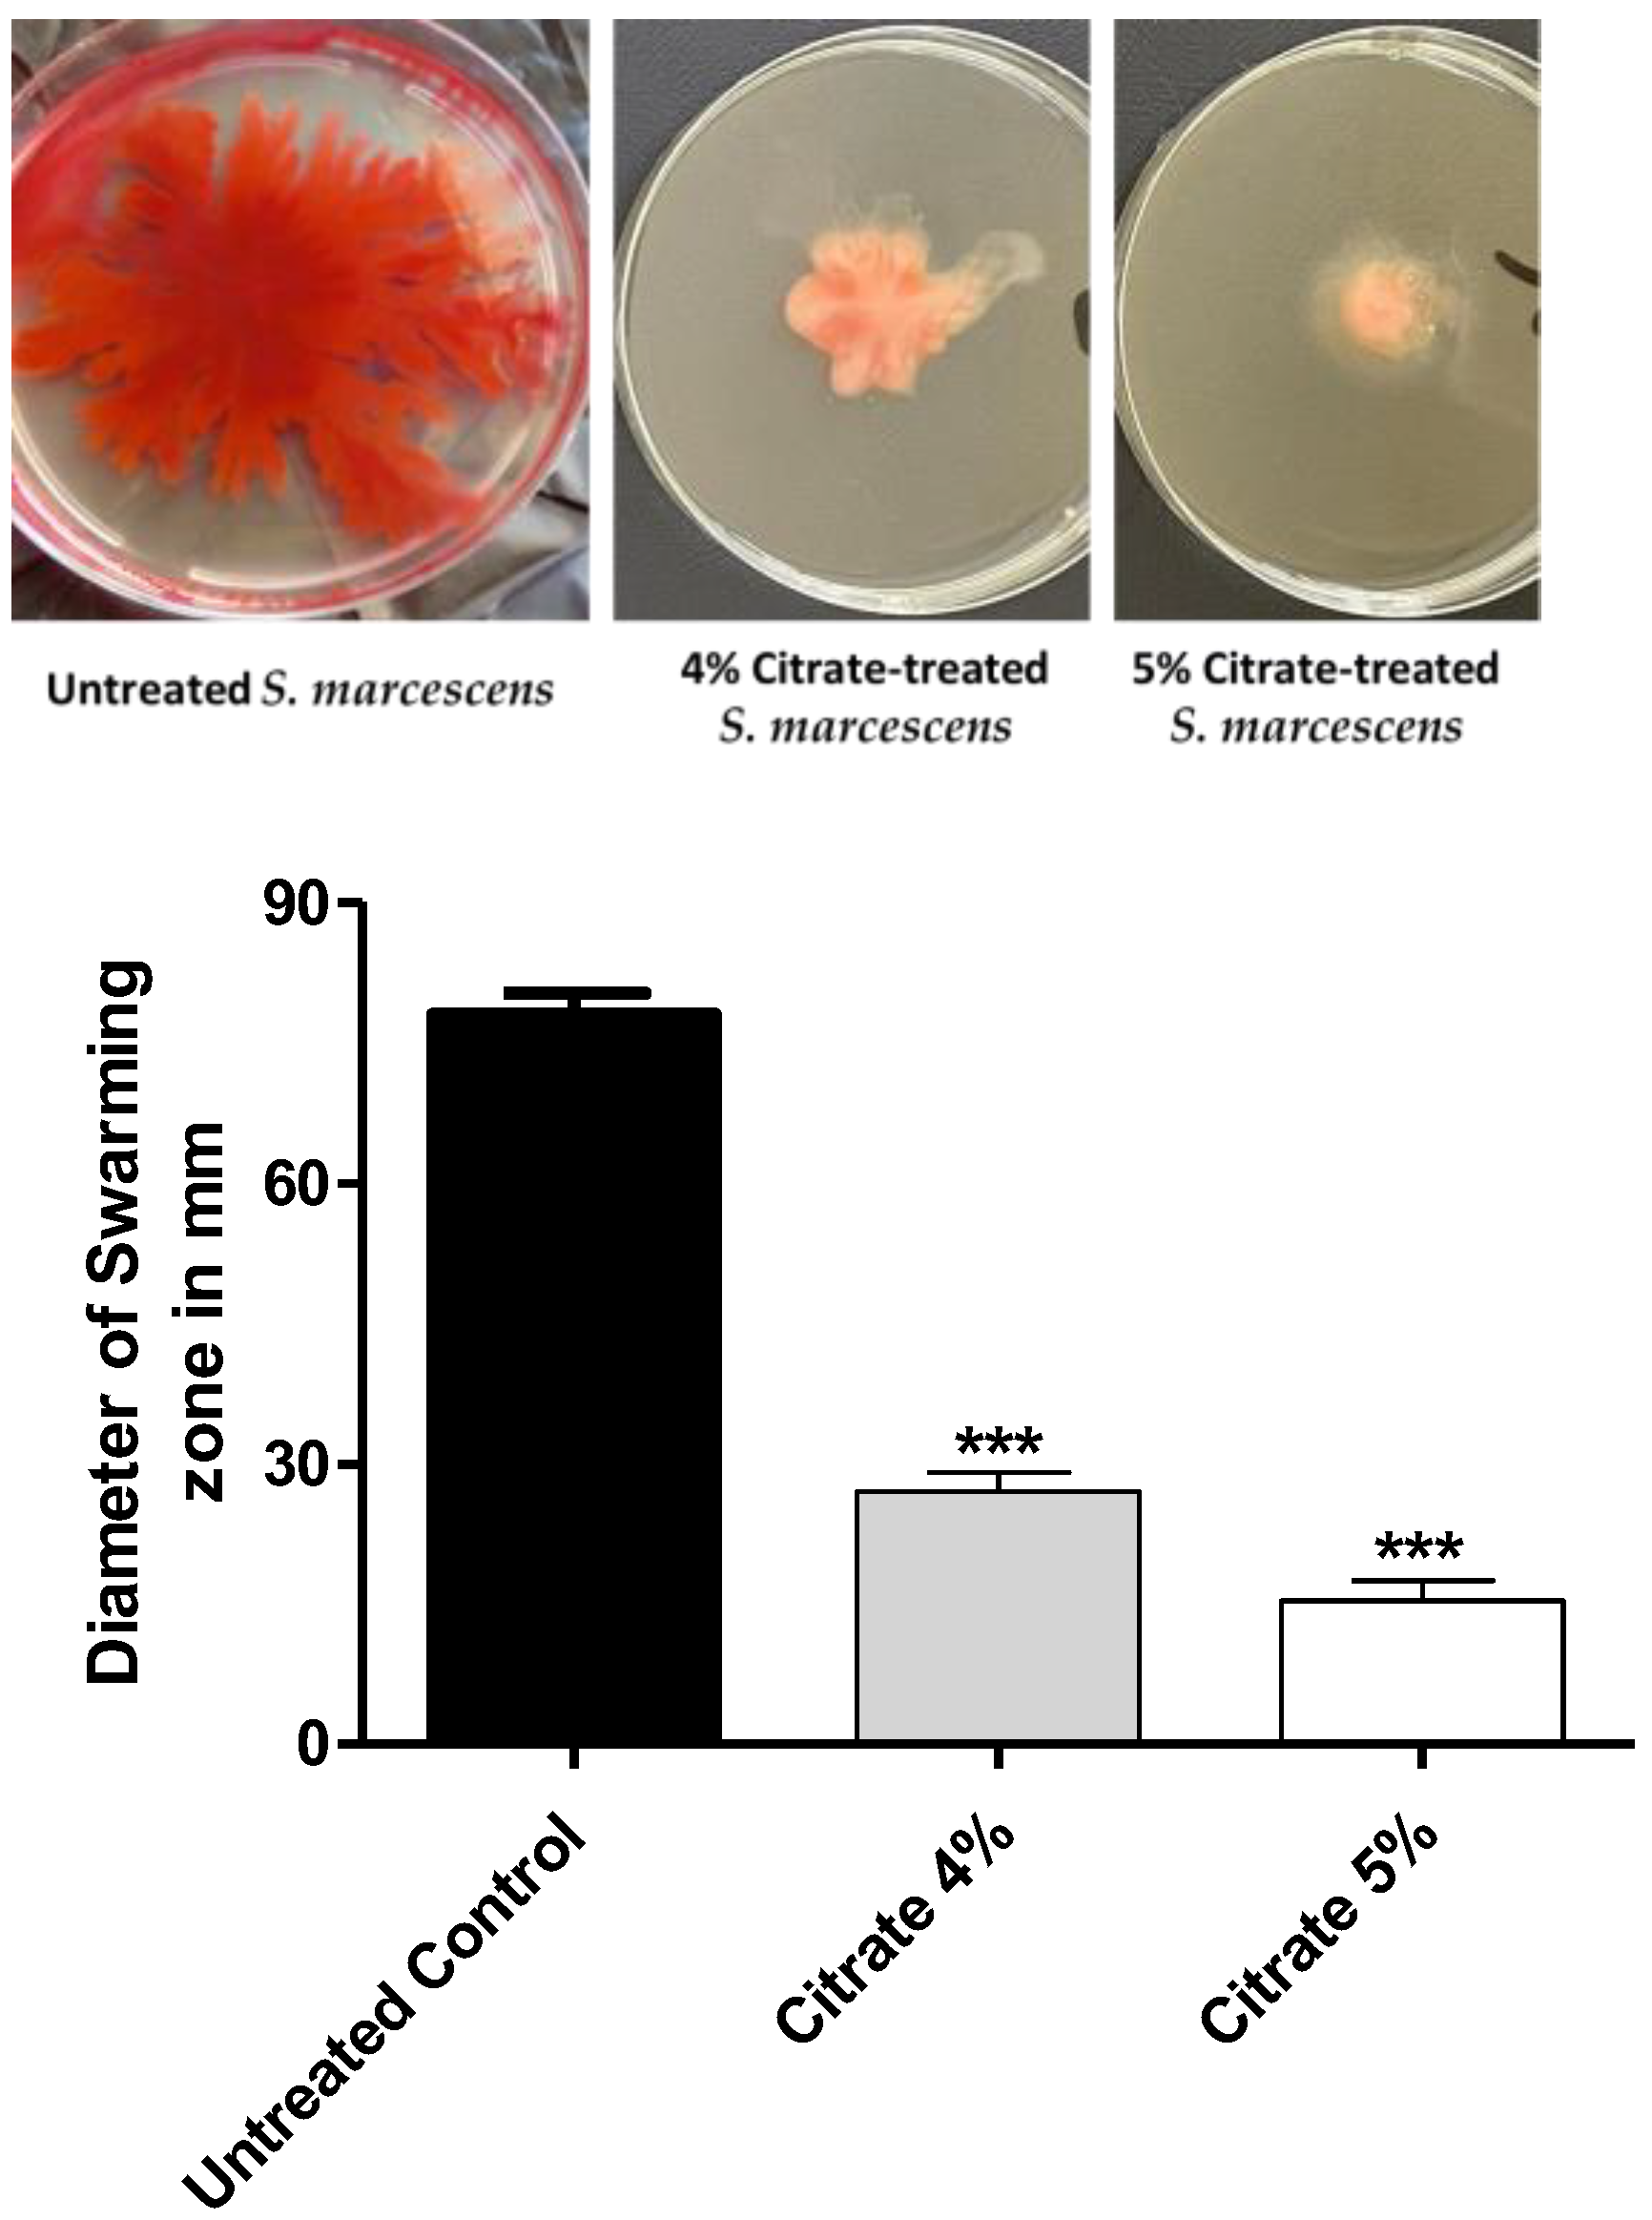
Biology 12 00504 g003

Diminishing the Pathogenesis of the Food-Borne Pathogen Serratia marcescens by Low Doses of Sodium Citrate
Simple Summary
Abstract
1. Introduction
2. Materials and Methods
2.1. Bacteria, Media, and Growth Conditions
2.2. Effect of Sodium Citrate on Bacterial Growth
2.3. Effect of Sodium Citrate on Biofilm Formation
2.4. Effect of Sodium Citrate on Motility
2.5. Anti-Proteolytic Activity Assay
2.6. Effect of Sodium Citrate on the Production of Prodigiosin
2.7. Effect of Citrate on the Expression of Virulence-Encoding Genes
2.8. Histopathological Evaluation of Sodium Citrate Effect on the Liver and Kidney Tissues of the Infected Mice
2.9. In Silico Molecular Docking Study
2.10. Statistical Evaluation
3. Results
3.1. Sodium Citrate at 4% or 5% Has No Effect on the Bacterial Growth
3.2. Sodium Citrate Diminishes the Formation of Biofilms
3.3. Sodium Citrate Diminishes the Swarming Motility of S. marcescens
3.4. Sodium Citrate Decreases the Activity of Protease
3.5. Sodium Citrate Decreases the Production of Prodigiosin
3.6. Sodium Citrate Downregulates the Expression of Virulence Genes
3.7. Sodium Citrate Alleviates the Histopathological Changes in Liver and Renal
3.8. In Silico Competition on QS Targets
4. Discussion
5. Conclusions
Author Contributions
Funding
Institutional Review Board Statement
Informed Consent Statement
Data Availability Statement
Conflicts of Interest
References
- Lyerly, D.M.; Kreger, A.S. Importance of serratia protease in the pathogenesis of experimental Serratia marcescens pneumonia. Infect. Immun. 1983, 40, 113–119. [Google Scholar] [CrossRef] [PubMed]
- Allen, J.L.; Doidge, N.P.; Bushell, R.N.; Browning, G.F.; Marenda, M.S. Healthcare-associated infections caused by chlorhexidine-tolerant Serratia marcescens carrying a promiscuous IncHI2 multi-drug resistance plasmid in a veterinary hospital. PLoS ONE 2022, 17, e0264848. [Google Scholar] [CrossRef] [PubMed]
- Tomanic, D.; Bozin, B.; Kladar, N.; Stanojevic, J.; Cabarkapa, I.; Stilinovic, N.; Apic, J.; Bozic, D.D.; Kovacevic, Z. Environmental Bovine Mastitis Pathogens: Prevalence, Antimicrobial Susceptibility, and Sensitivity to Thymus vulgaris L., Thymus serpyllum L., and Origanum vulgare L. Essential Oils. Antibiotics 2022, 11, 1077. [Google Scholar] [CrossRef] [PubMed]
- Han, R.; Xiang, R.; Li, J.; Wang, F.; Wang, C. High-level production of microbial prodigiosin: A review. J. Basic Microbiol. 2021, 61, 506–523. [Google Scholar] [CrossRef] [PubMed]
- Kim, S.B.; Jeon, Y.D.; Kim, J.H.; Kim, J.K.; Ann, H.W.; Choi, H.; Kim, M.H.; Song, J.E.; Ahn, J.Y.; Jeong, S.J. Risk factors for mortality in patients with Serratia marcescens bacteremia. Yonsei Med. J. 2015, 56, 348–354. [Google Scholar] [CrossRef]
- Åttman, E.; Korhonen, P.; Tammela, O.; Vuento, R.; Aittoniemi, J.; Syrjänen, J.; Mattila, E.; Österblad, M.; Huttunen, R. A Serratia marcescens outbreak in a neonatal intensive care unit was successfully managed by rapid hospital hygiene interventions and screening. Acta Paediatr. 2018, 107, 425–429. [Google Scholar] [CrossRef]
- Melo, D.; Souza, B.; Nascimento, J.; Amorim, A.; Medeiros, L.; Mattoso, J. A reddish problem: Antibiotic-resistant Serratia marcescens in dairy food commercialized in Rio de Janeiro. Int. Food Res. J. 2018, 25, 880–883. [Google Scholar]
- Hume, E.B.; Conerly, L.L.; Moreau, J.M.; Cannon, B.M.; Engel, L.S.; Stroman, D.W.; Hill, J.M.; O’Callaghan, R.J. Serratia marcescens keratitis: Strain-specific corneal pathogenesis in rabbits. Curr. Eye Res. 1999, 19, 525–532. [Google Scholar] [CrossRef]
- Obana, Y.; Shibata, K.; Nishino, T. Adherence of Serratia marcescens in the pathogenesis of urinary tract infections in diabetic mice. J. Med. Microbiol. 1991, 35, 93–97. [Google Scholar] [CrossRef]
- Stock, I.; Burak, S.; Sherwood, K.J.; Gruger, T.; Wiedemann, B. Natural antimicrobial susceptibilities of strains of ‘unusual’ Serratia species: S. ficaria, S. fonticola, S. odorifera, S. plymuthica and S. rubidaea. J. Antimicrob. Chemother. 2003, 51, 865–885. [Google Scholar] [CrossRef]
- Iguchi, A.; Nagaya, Y.; Pradel, E.; Ooka, T.; Ogura, Y.; Katsura, K.; Kurokawa, K.; Oshima, K.; Hattori, M.; Parkhill, J.; et al. Genome evolution and plasticity of Serratia marcescens, an important multidrug-resistant nosocomial pathogen. Genome Biol. Evol. 2014, 6, 2096–2110. [Google Scholar] [CrossRef] [PubMed]
- Gravrand, V.; Ariey, F.; Terracol, L.; Poupet, H.; Doloy, A.; Poyart, C.; Mammeri, H. Frameshift mutation (690delG) in cpxA contributes to the extensive drug resistance of a Serratia marcescens clinical isolate. J. Antimicrob. Chemother. 2022, 77, 1611–1616. [Google Scholar] [CrossRef] [PubMed]
- Hou, J.; Mao, D.; Zhang, Y.; Huang, R.; Li, L.; Wang, X.; Luo, Y. Long-term spatiotemporal variation of antimicrobial resistance genes within the Serratia marcescens population and transmission of S. marcescens revealed by public whole-genome datasets. J. Hazard Mater. 2022, 423, 127220. [Google Scholar] [CrossRef] [PubMed]
- Niu, H.; Sun, Y.; Zhang, Z.; Zhao, D.; Wang, N.; Wang, L.; Guo, H. The endophytic bacterial entomopathogen Serratia marcescens promotes plant growth and improves resistance against Nilaparvata lugens in rice. Microbiol. Res. 2022, 256, 126956. [Google Scholar] [CrossRef] [PubMed]
- Thabit, A.K.; Eljaaly, K.; Zawawi, A.; Ibrahim, T.S.; Eissa, A.G.; Elbaramawi, S.S.; Hegazy, W.A.H.; Elfaky, M.A. Muting Bacterial Communication: Evaluation of Prazosin Anti-Quorum Sensing Activities against Gram-Negative Bacteria Pseudomonas aeruginosa, Proteus mirabilis, and Serratia marcescens. Biology 2022, 11, 1349. [Google Scholar] [CrossRef] [PubMed]
- Alandiyjany, M.N.; Abdelaziz, A.S.; Abdelfattah-Hassan, A.; Hegazy, W.A.H.; Hassan, A.A.; Elazab, S.T.; Mohamed, E.A.A.; El-Shetry, E.S.; Saleh, A.A.; ElSawy, N.A.; et al. Novel In Vivo Assessment of Antimicrobial Efficacy of Ciprofloxacin Loaded Mesoporous Silica Nanoparticles against Salmonella typhimurium Infection. Pharmaceuticals 2022, 15, 357. [Google Scholar] [CrossRef]
- Abd El-Hamid, M.I.; Sewid, A.H.; Samir, M.; Hegazy, W.A.H.; Bahnass, M.M.; Mosbah, R.A.; Ghaith, D.M.; Khalifa, E.; Ramadan, H.; Alshareef, W.A.; et al. Clonal Diversity and Epidemiological Characteristics of ST239-MRSA Strains. Front. Cell. Infect. Microbiol. 2022, 12, 82045. [Google Scholar] [CrossRef]
- Abu Lila, A.S.; Alharby, T.N.; Alanazi, J.; Alanazi, M.; Abdallah, M.H.; Rizvi, S.M.D.; Moin, A.; Khafagy, E.-S.; Tabrez, S.; Al Balushi, A.A. Clinical Resistant Strains of Enterococci and Their Correlation to Reduced Susceptibility to Biocides: Phenotypic and Genotypic Analysis of Macrolides, Lincosamides, and Streptogramins. Antibiotics 2023, 12, 461. [Google Scholar] [CrossRef]
- Hegazy, W.A.H.; Rajab, A.A.H.; Abu Lila, A.S.; Abbas, H.A. Anti-diabetics and antimicrobials: Harmony of mutual interplay. World J. Diabetes 2021, 12, 1832–1855. [Google Scholar] [CrossRef]
- Lila, A.S.A.; Rajab, A.A.; Abdallah, M.H.; Rizvi, S.M.D.; Moin, A.; Khafagy, E.-S.; Tabrez, S.; Hegazy, W.A. Biofilm Lifestyle in Recurrent Urinary Tract Infections. Life 2023, 13, 148. [Google Scholar] [CrossRef]
- Khayyat, A.N.; Hegazy, W.A.H.; Shaldam, M.A.; Mosbah, R.; Almalki, A.J.; Ibrahim, T.S.; Khayat, M.T.; Khafagy, E.S.; Soliman, W.E.; Abbas, H.A. Xylitol Inhibits Growth and Blocks Virulence in Serratia marcescens. Microorganisms 2021, 9, 1083. [Google Scholar] [CrossRef] [PubMed]
- Van Houdt, R.; Givskov, M.; Michiels, C.W. Quorum sensing in Serratia. FEMS Microbiol. Rev. 2007, 31, 407–424. [Google Scholar] [CrossRef] [PubMed]
- Abbas, H.A.; Hegazy, W.A.H. Repurposing anti-diabetic drug “Sitagliptin” as a novel virulence attenuating agent in Serratia marcescens. PLoS ONE 2020, 15, e0231625. [Google Scholar] [CrossRef] [PubMed]
- Ang, S.; Horng, Y.T.; Shu, J.C.; Soo, P.C.; Liu, J.H.; Yi, W.C.; Lai, H.C.; Luh, K.T.; Ho, S.W.; Swift, S. The role of RsmA in the regulation of swarming motility in Serratia marcescens. J. Biomed. Sci. 2001, 8, 160–169. [Google Scholar] [CrossRef]
- Nicholson, W.L.; Leonard, M.T.; Fajardo-Cavazos, P.; Panayotova, N.; Farmerie, W.G.; Triplett, E.W.; Schuerger, A.C. Complete Genome Sequence of Serratia liquefaciens Strain ATCC 27592. Genome Announc. 2013, 1, e00548-13. [Google Scholar] [CrossRef]
- Zhou, W.; Li, J.; Chen, J.; Liu, X.; Xiang, T.; Zhang, L.; Wan, Y. The red pigment prodigiosin is not an essential virulence factor in entomopathogenic Serratia marcescens. J. Invertebr. Pathol. 2016, 136, 92–94. [Google Scholar] [CrossRef]
- Almalki, A.J.; Ibrahim, T.S.; Elhady, S.S.; Darwish, K.M.; Hegazy, W.A.H. Repurposing α-Adrenoreceptor Blockers as Promising Anti-Virulence Agents in Gram-Negative Bacteria. Antibiotics 2022, 11, 178. [Google Scholar]
- Almalki, A.J.; Ibrahim, T.S.; Elhady, S.S.; Hegazy, W.A.H.; Darwish, K.M. Computational and Biological Evaluation of β-Adrenoreceptor Blockers as Promising Bacterial Anti-Virulence Agents. Pharmaceuticals 2022, 15, 110. [Google Scholar]
- Askoura, M.; Almalki, A.J.; Lila, A.S.A.; Almansour, K.; Alshammari, F.; Khafagy, E.-S.; Ibrahim, T.S.; Hegazy, W.A.H. Alteration of Salmonella enterica Virulence and Host Pathogenesis through Targeting sdiA by Using the CRISPR-Cas9 System. Microorganisms 2021, 9, 2564. [Google Scholar] [CrossRef]
- Jiang, T.; Li, M. Quorum sensing inhibitors: A patent review. Expert Opin. Ther. Pat. 2013, 23, 867–894. [Google Scholar] [CrossRef]
- Parsek, M.R.; Val, D.L.; Hanzelka, B.L.; Cronan, J.E., Jr.; Greenberg, E.P. Acyl homoserine-lactone quorum-sensing signal generation. Proc. Natl. Acad. Sci. USA 1999, 96, 4360–4365. [Google Scholar] [CrossRef] [PubMed]
- Eberl, L.; Winson, M.K.; Sternberg, C.; Stewart, G.S.; Christiansen, G.; Chhabra, S.R.; Bycroft, B.; Williams, P.; Molin, S.; Givskov, M. Involvement of N-acyl-L-hormoserine lactone autoinducers in controlling the multicellular behaviour of Serratia liquefaciens. Mol. Microbiol. 1996, 20, 127–136. [Google Scholar] [CrossRef] [PubMed]
- Coulthurst, S.J.; Lilley, K.S.; Salmond, G.P. Genetic and proteomic analysis of the role of luxS in the enteric phytopathogen, Erwinia carotovora. Mol. Plant Pathol. 2006, 7, 31–45. [Google Scholar] [CrossRef] [PubMed]
- Coulthurst, S.J.; Williamson, N.R.; Harris, A.K.P.; Spring, D.R.; Salmond, G.P.C. Metabolic and regulatory engineering of Serratia marcescens: Mimicking phage-mediated horizontal acquisition of antibiotic biosynthesis and quorum-sensing capacities. Microbiology 2006, 152, 1899–1911. [Google Scholar] [CrossRef]
- Hegazy, W.A.H.; Khayat, M.T.; Ibrahim, T.S.; Youns, M.; Mosbah, R.; Soliman, W.E. Repurposing of antidiabetics as Serratia marcescens virulence inhibitors. Braz. J. Microbiol. 2021, 52, 627–638. [Google Scholar] [CrossRef]
- Ramanathan, S.; Ravindran, D.; Arunachalam, K.; Arumugam, V.R. Inhibition of quorum sensing-dependent biofilm and virulence genes expression in environmental pathogen Serratia marcescens by petroselinic acid. Antonie Van Leeuwenhoek 2018, 111, 501–515. [Google Scholar] [CrossRef]
- Srinivasan, R.; Mohankumar, R.; Kannappan, A.; Karthick Raja, V.; Archunan, G.; Karutha Pandian, S.; Ruckmani, K.; Veera Ravi, A. Exploring the Anti-quorum Sensing and Antibiofilm Efficacy of Phytol against Serratia marcescens Associated Acute Pyelonephritis Infection in Wistar Rats. Front. Cell Infect. Microbiol. 2017, 7, 498. [Google Scholar] [CrossRef]
- Chen, G.; Swem, L.R.; Swem, D.L.; Stauff, D.L.; O’Loughlin, C.T.; Jeffrey, P.D.; Bassler, B.L.; Hughson, F.M. A strategy for antagonizing quorum sensing. Mol. Cell 2011, 42, 199–209. [Google Scholar] [CrossRef]
- Almalki, A.J.; Ibrahim, T.S.; Taher, E.S.; Mohamed, M.F.A.; Youns, M.; Hegazy, W.A.H.; Al-Mahmoudy, A.M.M. Synthesis, Antimicrobial, Anti-Virulence and Anticancer Evaluation of New 5(4H)-Oxazolone-Based Sulfonamides. Molecules 2022, 27, 671. [Google Scholar] [CrossRef]
- Elfaky, M.A.; Thabit, A.K.; Eljaaly, K.; Zawawi, A.; Abdelkhalek, A.S.; Almalki, A.J.; Ibrahim, T.S.; Hegazy, W.A.H. Controlling of Bacterial Virulence: Evaluation of Anti-Virulence Activities of Prazosin against Salmonella enterica. Antibiotics 2022, 11, 1585. [Google Scholar] [CrossRef]
- Khayat, M.T.; Ibrahim, T.S.; Khayyat, A.N.; Alharbi, M.; Shaldam, M.A.; Mohammad, K.A.; Khafagy, E.-S.; El-damasy, D.A.; Hegazy, W.A.H.; Abbas, H.A. Sodium Citrate Alleviates Virulence in Pseudomonas aeruginosa. Microorganisms 2022, 10, 1046. [Google Scholar] [CrossRef] [PubMed]
- Thabit, A.K.; Eljaaly, K.; Zawawi, A.; Ibrahim, T.S.; Eissa, A.G.; Elbaramawi, S.S.; Hegazy, W.A.H.; Elfaky, M.A. Silencing of Salmonella typhimurium Pathogenesis: Atenolol Acquires Efficient Anti-Virulence Activities. Microorganisms 2022, 10, 1976. [Google Scholar] [CrossRef] [PubMed]
- Brackman, G.; Cos, P.; Maes, L.; Nelis, H.J.; Coenye, T. Quorum sensing inhibitors increase the susceptibility of bacterial biofilms to antibiotics in vitro and in vivo. Antimicrob. Agents Chemother. 2011, 55, 2655–2661. [Google Scholar] [CrossRef]
- Dong, Y.H.; Wang, L.H.; Xu, J.L.; Zhang, H.B.; Zhang, X.F.; Zhang, L.H. Quenching quorum-sensing-dependent bacterial infection by an N-acyl homoserine lactonase. Nature 2001, 411, 813–817. [Google Scholar] [CrossRef] [PubMed]
- Li, Y.H.; Tian, X. Quorum sensing and bacterial social interactions in biofilms. Sensors 2012, 12, 2519–2538. [Google Scholar] [CrossRef]
- Hansen, M.R.; Jakobsen, T.H.; Bang, C.G.; Cohrt, A.E.; Hansen, C.L.; Clausen, J.W.; Le Quement, S.T.; Tolker-Nielsen, T.; Givskov, M.; Nielsen, T.E. Triazole-containing N-acyl homoserine lactones targeting the quorum sensing system in Pseudomonas aeruginosa. Bioorganic Med. Chem. 2015, 23, 1638–1650. [Google Scholar] [CrossRef] [PubMed]
- Krishnan, T.; Yin, W.F.; Chan, K.G. Inhibition of quorum sensing-controlled virulence factor production in Pseudomonas aeruginosa PAO1 by Ayurveda spice clove (Syzygium aromaticum) bud extract. Sensors 2012, 12, 4016–4030. [Google Scholar] [CrossRef] [PubMed]
- Rasmussen, T.B.; Givskov, M. Quorum-sensing inhibitors as anti-pathogenic drugs. Int. J. Med. Microbiol. 2006, 296, 149–161. [Google Scholar] [CrossRef] [PubMed]
- Hegazy, W.A.H.; Salem, I.M.; Alotaibi, H.F.; Khafagy, E.-S.; Ibrahim, D. Terazosin Interferes with Quorum Sensing and Type Three Secretion System and Diminishes the Bacterial Espionage to Mitigate the Salmonella Typhimurium Pathogenesis. Antibiotics 2022, 11, 465. [Google Scholar] [CrossRef]
- Saqr, A.A.; Aldawsari, M.F.; Khafagy, E.-S.; Shaldam, M.A.; Hegazy, W.A.H.; Abbas, H.A. A Novel Use of Allopurinol as A Quorum-Sensing Inhibitor in Pseudomonas aeruginosa. Antibiotics 2021, 10, 1385. [Google Scholar] [CrossRef]
- Garcia-Contreras, R. Is Quorum Sensing Interference a Viable Alternative to Treat Pseudomonas aeruginosa Infections? Front. Microbiol. 2016, 7, 1454. [Google Scholar] [CrossRef] [PubMed]
- Cegelski, L.; Marshall, G.R.; Eldridge, G.R.; Hultgren, S.J. The biology and future prospects of antivirulence therapies. Nat. Rev. Microbiol. 2008, 6, 17–27. [Google Scholar] [CrossRef] [PubMed]
- Aldawsari, M.F.; Alalaiwe, A.; Khafagy, E.S.; Al Saqr, A.; Alshahrani, S.M.; Alsulays, B.B.; Alshehri, S.; Abu Lila, A.S.; Danish Rizvi, S.M.; Hegazy, W.A.H. Efficacy of SPG-ODN 1826 Nanovehicles in Inducing M1 Phenotype through TLR-9 Activation in Murine Alveolar J774A.1 Cells: Plausible Nano-Immunotherapy for Lung Carcinoma. Int. J. Mol. Sci. 2021, 22, 6833. [Google Scholar] [CrossRef] [PubMed]
- Cavalu, S.; Elbaramawi, S.S.; Eissa, A.G.; Radwan, M.F.; Ibrahim, T.S.; Khafagy, E.-S.; Lopes, B.S.; Ali, M.A.M.; Hegazy, W.A.H.; Elfaky, M.A. Characterization of the Anti-Biofilm and Anti-Quorum Sensing Activities of the β-Adrenoreceptor Antagonist Atenolol against Gram-Negative Bacterial Pathogens. Int. J. Mol. Sci. 2022, 23, 13088. [Google Scholar]
- Kim, H.S.; Lee, S.H.; Byun, Y.; Park, H.D. 6-Gingerol reduces Pseudomonas aeruginosa biofilm formation and virulence via quorum sensing inhibition. Sci. Rep. 2015, 5, 8656. [Google Scholar] [CrossRef]
- Agha, K.A.; Abo-Dya, N.E.; Ibrahim, T.S.; Abdel-Aal, E.H.; Hegazy, W.A. Benzotriazole-Mediated Synthesis and Antibacterial Activity of Novel N-Acylcephalexins. Sci. Pharm. 2016, 84, 484–496. [Google Scholar] [CrossRef]
- Lee, J.H.; Cho, H.S.; Kim, Y.; Kim, J.A.; Banskota, S.; Cho, M.H.; Lee, J. Indole and 7-benzyloxyindole attenuate the virulence of Staphylococcus aureus. Appl. Microbiol. Biotechnol. 2013, 97, 4543–4552. [Google Scholar] [CrossRef]
- Aldawsari, M.F.; Khafagy, E.S.; Saqr, A.A.; Alalaiwe, A.; Abbas, H.A.; Shaldam, M.A.; Hegazy, W.A.H.; Goda, R.M. Tackling Virulence of Pseudomonas aeruginosa by the Natural Furanone Sotolon. Antibiotics 2021, 10, 871. [Google Scholar] [CrossRef]
- Youns, M.; Askoura, M.; Abbas, H.A.; Attia, G.H.; Khayyat, A.N.; Goda, R.M.; Almalki, A.J.; Khafagy, E.S.; Hegazy, W.A.H. Celastrol Modulates Multiple Signaling Pathways to Inhibit Proliferation of Pancreatic Cancer via DDIT3 and ATF3 Up-Regulation and RRM2 and MCM4 Down-Regulation. Onco Targets Ther. 2021, 14, 3849–3860. [Google Scholar] [CrossRef]
- Srinivasan, R.; Devi, K.R.; Kannappan, A.; Pandian, S.K.; Ravi, A.V. Piper betle and its bioactive metabolite phytol mitigates quorum sensing mediated virulence factors and biofilm of nosocomial pathogen Serratia marcescens in vitro. J. Ethnopharmacol. 2016, 193, 592–603. [Google Scholar] [CrossRef]
- Choo, J.H.; Rukayadi, Y.; Hwang, J.K. Inhibition of bacterial quorum sensing by vanilla extract. Lett. Appl. Microbiol. 2006, 42, 637–641. [Google Scholar] [CrossRef] [PubMed]
- Kumar, L.; Chhibber, S.; Kumar, R.; Kumar, M.; Harjai, K. Zingerone silences quorum sensing and attenuates virulence of Pseudomonas aeruginosa. Fitoterapia 2015, 102, 84–95. [Google Scholar] [CrossRef] [PubMed]
- Amiri, A.; Farshi-Marandi, P.; Shahedi, M. Impact of sodium citrate on structural properties of gluten. J. Food Sci. Technol. 2019, 56, 1090–1093. [Google Scholar] [CrossRef] [PubMed]
- Fiedler, J.; Smite, Z.; Suvi, S.; Timpmann, S.; Mooses, M.; Medijainen, L.; Unt, E.; Oopik, V. Impact of sodium citrate ingestion during recovery after strenuous exercise in the heat on heart rate variability: A randomized, crossover study. Physiol. Rep. 2022, 10, e15280. [Google Scholar] [CrossRef]
- Urwin, C.S.; Snow, R.J.; Condo, D.; Snipe, R.; Wadley, G.D.; Carr, A.J. Factors Influencing Blood Alkalosis and Other Physiological Responses, Gastrointestinal Symptoms, and Exercise Performance Following Sodium Citrate Supplementation: A Review. Int. J. Sport Nutr. Exerc. Metab. 2021, 31, 168–186. [Google Scholar] [CrossRef]
- Nagaoka, S.; Murata, S.; Kimura, K.; Mori, T.; Hojo, K. Antimicrobial activity of sodium citrate against Streptococcus pneumoniae and several oral bacteria. Lett. Appl. Microbiol. 2010, 51, 546–551. [Google Scholar] [CrossRef]
- Rosenblatt, J.; Reitzel, R.; Dvorak, T.; Jiang, Y.; Hachem, R.Y.; Raad, I.I. Glyceryl trinitrate complements citrate and ethanol in a novel antimicrobial catheter lock solution to eradicate biofilm organisms. Antimicrob. Agents Chemother. 2013, 57, 3555–3560. [Google Scholar] [CrossRef]
- Takla, T.A.; Zelenitsky, S.A.; Vercaigne, L.M. Effectiveness of a 30% ethanol/4% trisodium citrate locking solution in preventing biofilm formation by organisms causing haemodialysis catheter-related infections. J. Antimicrob. Chemother. 2008, 62, 1024–1026. [Google Scholar] [CrossRef][Green Version]
- Abbas, H.A.; Hegazy, W.A.H. Targeting the virulence factors of Serratia marcescens by ambroxol. Roum. Arch. Microbiol. Immunol. 2017, 76, 27–32. [Google Scholar]
- Khayyat, A.N.; Abbas, H.A.; Khayat, M.T.; Shaldam, M.A.; Askoura, M.; Asfour, H.Z.; Khafagy, E.-S.; Abu Lila, A.S.; Allam, A.N.; Hegazy, W.A.H. Secnidazole Is a Promising Imidazole Mitigator of Serratia marcescens Virulence. Microorganisms 2021, 9, 2333. [Google Scholar] [CrossRef]
- Khayat, M.T.; Abbas, H.A.; Ibrahim, T.S.; Khayyat, A.N.; Alharbi, M.; Darwish, K.M.; Elhady, S.S.; Khafagy, E.-S.; Safo, M.K.; Hegazy, W.A.H. Anti-Quorum Sensing Activities of Gliptins against Pseudomonas aeruginosa and Staphylococcus aureus. Biomedicines 2022, 10, 1169. [Google Scholar] [CrossRef] [PubMed]
- Abbas, H.A.; Goda, R.M. Sotolon is a natural virulence mitigating agent in Serratia marcescens. Arch. Microbiol. 2021, 203, 533–541. [Google Scholar] [CrossRef] [PubMed]
- Khayyat, A.N.; Abbas, H.A.; Mohamed, M.F.A.; Asfour, H.Z.; Khayat, M.T.; Ibrahim, T.S.; Youns, M.; Khafagy, E.-S.; Abu Lila, A.S.; Safo, M.K.; et al. Not Only Antimicrobial: Metronidazole Mitigates the Virulence of Proteus mirabilis Isolated from Macerated Diabetic Foot Ulcer. Appl. Sci. 2021, 11, 6847. [Google Scholar] [CrossRef]
- Askoura, M.; Youns, M.; Halim Hegazy, W.A. Investigating the influence of iron on Campylobacter jejuni transcriptome in response to acid stress. Microb. Pathog. 2020, 138, 103777. [Google Scholar] [CrossRef]
- Askoura, M.; Abbas, H.A.; Al Sadoun, H.; Abdulaal, W.H.; Abu Lila, A.S.; Almansour, K.; Alshammari, F.; Khafagy, E.-S.; Ibrahim, T.S.; Hegazy, W.A.H. Elevated Levels of IL-33, IL-17 and IL-25 Indicate the Progression from Chronicity to Hepatocellular Carcinoma in Hepatitis C Virus Patients. Pathogens 2022, 11, 57. [Google Scholar] [CrossRef]
- Khayat, M.T.; Ibrahim, T.S.; Darwish, K.M.; Khayyat, A.N.; Alharbi, M.; Khafagy, E.S.; Ali, M.A.M.; Hegazy, W.A.H.; Abbas, H.A. Hiring of the Anti-Quorum Sensing Activities of Hypoglycemic Agent Linagliptin to Alleviate the Pseudomonas aeruginosa Pathogenesis. Microorganisms 2022, 10, 2455. [Google Scholar] [CrossRef]
- Bertoni, M.; Kiefer, F.; Biasini, M.; Bordoli, L.; Schwede, T. Modeling protein quaternary structure of homo- and hetero-oligomers beyond binary interactions by homology. Sci. Rep. 2017, 7, 10480. [Google Scholar] [CrossRef]
- Studer, G.; Rempfer, C.; Waterhouse, A.M.; Gumienny, R.; Haas, J.; Schwede, T. QMEANDisCo-distance constraints applied on model quality estimation. Bioinformatics 2020, 36, 2647. [Google Scholar] [CrossRef]
- Studer, G.; Tauriello, G.; Bienert, S.; Biasini, M.; Johner, N.; Schwede, T. ProMod3-A versatile homology modelling toolbox. PLoS Comput. Biol. 2021, 17, e1008667. [Google Scholar] [CrossRef]
- Waterhouse, A.; Bertoni, M.; Bienert, S.; Studer, G.; Tauriello, G.; Gumienny, R.; Heer, F.T.; de Beer, T.A.P.; Rempfer, C.; Bordoli, L.; et al. SWISS-MODEL: Homology modelling of protein structures and complexes. Nucleic Acids Res. 2018, 46, W296–W303. [Google Scholar] [CrossRef]
- Bienert, S.; Waterhouse, A.; de Beer, T.A.; Tauriello, G.; Studer, G.; Bordoli, L.; Schwede, T. The SWISS-MODEL Repository-new features and functionality. Nucleic Acids Res. 2017, 45, D313–D319. [Google Scholar] [CrossRef] [PubMed]
- Chiaverini, A.; Di Domenico, M.; Del Matto, I.; Rossi, F.; Centorotola, G.; Cornacchia, A.; Cornacchione, N.; Petrone, D.; Iannitto, G.; Marino, L.; et al. Draft Genome Sequence of Serratia rubidaea, a Potential Opportunistic Pathogen Isolated from Food in Italy. Microbiol. Resour. Announc. 2021, 10, e0070721. [Google Scholar] [CrossRef] [PubMed]
- Liang, T.W.; Chen, S.Y.; Chen, Y.C.; Chen, C.H.; Yen, Y.H.; Wang, S.L. Enhancement of prodigiosin production by Serratia marcescens TKU011 and its insecticidal activity relative to food colorants. J. Food Sci. 2013, 78, M1743–M1751. [Google Scholar] [CrossRef] [PubMed]
- Wevers, E.; Moons, P.; Van Houdt, R.; Aertsen, A.; Michiels, C.W. Effects of quorum sensing on the spoilage of food by Serratia plymuthica. Commun. Agric. Appl. Biol. Sci. 2007, 72, 331–334. [Google Scholar]
- Daneshvar Alavi, H.E.; Truelstrup Hansen, L. Kinetics of biofilm formation and desiccation survival of Listeria monocytogenes in single and dual species biofilms with Pseudomonas fluorescens, Serratia proteamaculans or Shewanella baltica on food-grade stainless steel surfaces. Biofouling 2013, 29, 1253–1268. [Google Scholar] [CrossRef]
- Hegazy, W.A.H.; Henaway, M. Hepatitis C virus pathogenesis: Serum IL-33 level indicates liver damage. Afr. J. Microbiol. Res. 2015, 9, 1386–1393. [Google Scholar] [CrossRef]
- Askoura, M.; Hegazy, W.A.H. Ciprofloxacin interferes with Salmonella Typhimurium intracellular survival and host virulence through repression of Salmonella pathogenicity island-2 (SPI-2) genes expression. Pathog. Dis. 2020, 78, ftaa011. [Google Scholar] [CrossRef]
- Alshahrani, S.M.; Khafagy, E.-S.; Riadi, Y.; Al Saqr, A.; Alfadhel, M.M.; Hegazy, W.A. Amphotericin B-PEG Conjugates of ZnO Nanoparticles: Enhancement Antifungal Activity with Minimal Toxicity. Pharmaceutics 2022, 14, 1646. [Google Scholar] [CrossRef]
- Chu, L.; Zhou, X.; Shen, Y.; Yu, Y. Inhibitory effect of trisodium citrate on biofilms formed by Klebsiella pneumoniae. J. Glob. Antimicrob. Resist. 2020, 22, 452–456. [Google Scholar] [CrossRef]
- Harjai, K.; Kumar, R.; Singh, S. Garlic blocks quorum sensing and attenuates the virulence of Pseudomonas aeruginosa. FEMS Immunol. Med. Microbiol. 2010, 58, 161–168. [Google Scholar] [CrossRef]
- Issac Abraham, S.V.; Palani, A.; Ramaswamy, B.R.; Shunmugiah, K.P.; Arumugam, V.R. Antiquorum sensing and antibiofilm potential of Capparis spinosa. Arch. Med. Res. 2011, 42, 658–668. [Google Scholar] [CrossRef] [PubMed]
- Reitzel, R.A.; Rosenblatt, J.; Hirsh-Ginsberg, C.; Murray, K.; Chaftari, A.M.; Hachem, R.; Raad, I. In Vitro Assessment of the Antimicrobial Efficacy of Optimized Nitroglycerin-Citrate-Ethanol as a Nonantibiotic, Antimicrobial Catheter Lock Solution for Prevention of Central Line-Associated Bloodstream Infections. Antimicrob. Agents Chemother. 2016, 60, 5175–5181. [Google Scholar] [CrossRef] [PubMed]
- Hentzer, M.; Riedel, K.; Rasmussen, T.B.; Heydorn, A.; Andersen, J.B.; Parsek, M.R.; Rice, S.A.; Eberl, L.; Molin, S.; Hoiby, N.; et al. Inhibition of quorum sensing in Pseudomonas aeruginosa biofilm bacteria by a halogenated furanone compound. Microbiology 2002, 148, 87–102. [Google Scholar] [CrossRef]
- Rutherford, S.T.; Bassler, B.L. Bacterial quorum sensing: Its role in virulence and possibilities for its control. Cold Spring Harb. Perspect. Med. 2012, 2, a012427. [Google Scholar] [CrossRef] [PubMed]
- Hoiby, N.; Bjarnsholt, T.; Givskov, M.; Molin, S.; Ciofu, O. Antibiotic resistance of bacterial biofilms. Int. J. Antimicrob. Agents 2010, 35, 322–332. [Google Scholar] [CrossRef] [PubMed]
- Lopez, D.; Vlamakis, H.; Kolter, R. Biofilms. Cold Spring Harb. Perspect. Biol. 2010, 2, a000398. [Google Scholar] [CrossRef] [PubMed]
- Diard, M.; Hardt, W.D. Evolution of bacterial virulence. FEMS Microbiol. Rev. 2017, 41, 679–697. [Google Scholar] [CrossRef]
- Groisman, E.A.; Duprey, A.; Choi, J. How the PhoP/PhoQ System Controls Virulence and Mg(2+) Homeostasis: Lessons in Signal Transduction, Pathogenesis, Physiology, and Evolution. Microbiol. Mol. Biol. Rev. 2021, 85, e0017620. [Google Scholar] [CrossRef]
- Hall-Stoodley, L.; Costerton, J.W.; Stoodley, P. Bacterial biofilms: From the natural environment to infectious diseases. Nat. Rev. Microbiol. 2004, 2, 95–108. [Google Scholar] [CrossRef]
- Wolska, K.I.; Grudniak, A.M.; Rudnicka, Z.; Markowska, K. Genetic control of bacterial biofilms. J. Appl. Genet. 2016, 57, 225–238. [Google Scholar] [CrossRef]
- Hegazy, W.A.H.; Abbas, H.A. Evaluation of the role of SsaV ‘Salmonella pathogenicity island-2 dependent type III secretion system components on the virulence behavior of Salmonella enterica serovar Typhimurium. Afr. J. Biotechnol. 2017, 16, 718–726. [Google Scholar] [CrossRef]
- Brothers, K.M.; Stella, N.A.; Romanowski, E.G.; Kowalski, R.P.; Shanks, R.M. EepR Mediates Secreted-Protein Production, Desiccation Survival, and Proliferation in a Corneal Infection Model. Infect. Immun. 2015, 83, 4373–4382. [Google Scholar] [CrossRef]
- El-Tahawy, A.T. Bacteriology of diabetic foot. Saudi. Med. J. 2000, 21, 344–347. [Google Scholar] [PubMed]
- Lin, C.S.; Tsai, Y.H.; Chang, C.J.; Tseng, S.F.; Wu, T.R.; Lu, C.C.; Wu, T.S.; Lu, J.J.; Horng, J.T.; Martel, J.; et al. An iron detection system determines bacterial swarming initiation and biofilm formation. Sci. Rep. 2016, 6, 36747. [Google Scholar] [CrossRef] [PubMed]
- Mobley, H.L.; Belas, R.; Lockatell, V.; Chippendale, G.; Trifillis, A.L.; Johnson, D.E.; Warren, J.W. Construction of a flagellum-negative mutant of Proteus mirabilis: Effect on internalization by human renal epithelial cells and virulence in a mouse model of ascending urinary tract infection. Infect. Immun. 1996, 64, 5332–5340. [Google Scholar] [CrossRef] [PubMed]
- Liaw, S.J.; Lai, H.C.; Ho, S.W.; Luh, K.T.; Wang, W.B. Role of RsmA in the regulation of swarming motility and virulence factor expression in Proteus mirabilis. J. Med. Microbiol. 2003, 52, 19–28. [Google Scholar] [CrossRef] [PubMed]
- Pena, R.T.; Blasco, L.; Ambroa, A.; Gonzalez-Pedrajo, B.; Fernandez-Garcia, L.; Lopez, M.; Bleriot, I.; Bou, G.; Garcia-Contreras, R.; Wood, T.K.; et al. Relationship Between Quorum Sensing and Secretion Systems. Front. Microbiol. 2019, 10, 1100. [Google Scholar] [CrossRef]

| Gene | Sequence (5′–3′) | Gene Significance | Reference |
|---|---|---|---|
| fimC | For: AAGATCGCACCGTACAAACC Rev: TTTGCACCGCATAGTTCAAG | Fimbria (adhesion) | [23,54] |
| flhD | For: TGTCGGGATGGGGAATATGG Rev: CGATAGCTCTTGCAGTAAATGG | Flagella (motility) | [23,54] |
| bsmB | For: CCGCCTGCAAGAAAGAACTT Rev: AGAGATCGACGGTCAGTTCC | Type I pilus (adhesion) | [23,54] |
| pigB | For: GAACATGTTGGCAATGAAAA Rev: ATGTAACCCAGGAATTGCAC | Motility | [23,54] |
| rssB | For: TAACGAACTGCTGATGCTGT Rev: GATCTTGCGCCGTAAATTAT | Motility | [23,54] |
| shlA | For: GCGGCGATAACTATCAAAAT Rev: ATTGCCAGGAGTAGAACCAG | Pore forming (hemolysis) | [23,54] |
| rplU | For: GCTTGGAAAAGCTGGACATC Rev: TACGGTGGTGTTTACGACGA | Housekeeping gene | [23,54] |
| Ligand | S Score (Kcal/mol) | H-Bond Interactions | Hydrophobic Interactions |
|---|---|---|---|
| Citrate | −5.0162 | Ala34, Asn49, Trp81, Ser124 | Ala32, Phe44, Asn49, Tyr57, Leu69, Trp81 |
| HLC | −6.9484 | Trp53 | Ala32, Phe44, Tyr57, Trp81, Ile105, Val122, Ser124 |
Disclaimer/Publisher’s Note: The statements, opinions and data contained in all publications are solely those of the individual author(s) and contributor(s) and not of MDPI and/or the editor(s). MDPI and/or the editor(s) disclaim responsibility for any injury to people or property resulting from any ideas, methods, instructions or products referred to in the content. |
© 2023 by the authors. Licensee MDPI, Basel, Switzerland. This article is an open access article distributed under the terms and conditions of the Creative Commons Attribution (CC BY) license (https://creativecommons.org/licenses/by/4.0/).
Share and Cite
Khayat, M.T.; Elbaramawi, S.S.; Nazeih, S.I.; Safo, M.K.; Khafagy, E.-S.; Ali, M.A.M.; Abbas, H.A.; Hegazy, W.A.H.; Seleem, N.M. Diminishing the Pathogenesis of the Food-Borne Pathogen Serratia marcescens by Low Doses of Sodium Citrate. Biology 2023, 12, 504. https://doi.org/10.3390/biology12040504
Khayat MT, Elbaramawi SS, Nazeih SI, Safo MK, Khafagy E-S, Ali MAM, Abbas HA, Hegazy WAH, Seleem NM. Diminishing the Pathogenesis of the Food-Borne Pathogen Serratia marcescens by Low Doses of Sodium Citrate. Biology. 2023; 12(4):504. https://doi.org/10.3390/biology12040504
Chicago/Turabian StyleKhayat, Maan T., Samar S. Elbaramawi, Shaimaa I. Nazeih, Martin K. Safo, El-Sayed Khafagy, Mohamed A. M. Ali, Hisham A. Abbas, Wael A. H. Hegazy, and Noura M. Seleem. 2023. "Diminishing the Pathogenesis of the Food-Borne Pathogen Serratia marcescens by Low Doses of Sodium Citrate" Biology 12, no. 4: 504. https://doi.org/10.3390/biology12040504
APA StyleKhayat, M. T., Elbaramawi, S. S., Nazeih, S. I., Safo, M. K., Khafagy, E.-S., Ali, M. A. M., Abbas, H. A., Hegazy, W. A. H., & Seleem, N. M. (2023). Diminishing the Pathogenesis of the Food-Borne Pathogen Serratia marcescens by Low Doses of Sodium Citrate. Biology, 12(4), 504. https://doi.org/10.3390/biology12040504

